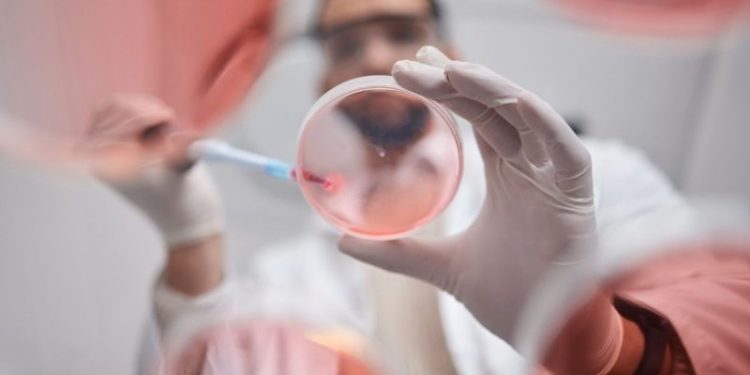
Pharma Market Forecast: Top Trends for Pharma in 2025

The pharmaceutical industry is poised for a dynamic year in 2025. A confluence of positive trends suggests a brighter outlook ahead after declining earnings in recent years.
According to ZS consultant Cody Powers, lower interest rates could increase investment in biopharma, boosting research and development (R&D) into promising new indications, mergers and acquisitions (M&A) and clinical trials.
Industry executives polled for Deloitte’s 2025 life science outlook anticipate revenue growth and margin expansion, leading to increased investment in key therapeutic areas such as oncology, immunology, neurology and, of course, treatments for obesity and diabetes. This renewed focus on innovation, coupled with a changing regulatory environment, is expected to drive interest in the sector that could reshape the competitive landscape.
Key therapeutic areas in 2025
PurpleLab data (via Axios) shows roughly a 10 percent increase in sales for GLP-1s in 2024, with continued growth predicted for 2025 due to sustained demand, according to Evaluate’s 2025 Pharma Preview.
After exceeding US$1 billion in 2024, the most recent forward-looking projections of GLP-1 sales from industry leaders Novo Nordisk (NYSE:NVO) and Eli Lilly (NYSE:LLY) are strong, with Novo aiming to capture more than a third of the global market share of diabetes care in 2025.
To keep up with demand, both companies are addressing previous production constraints by expanding manufacturing capacity. Novo Nordisk acquired contract manufacturer Catalent in a US$16.5 billion deal, finalizing the sale in December 2024 and securing itself as a key player in the supply chain. Meanwhile, Eli Lilly is bolstering its internal manufacturing with a new US$4.5 billion manufacturing and research and development (R&D) center in Indiana slated to open in late 2027.
In the meantime, Lilly is also expanding its existing facility in Wisconsin and has reportedly partnered with CDMOs National Resilience and BSP Pharmaceuticals to meet immediate needs.
Beyond manufacturing, both companies are making strategic moves to maintain their market dominance amidst the entry of biosimilars from corporations like Teva Pharmaceuticals and pharma companies in China.
Eli Lilly’s partnership with digital health company Ro expands patient access to its medications via telehealth, while its lower-priced single-dose vials of Zepbound lower the cost barriers for the self-pay market.
Moreover, innovation remains a key driver. Eli Lilly is actively testing tirzepatide for indications against MASH and chronic kidney disease and its oral GLP-1 agonist orforglipron is in Phase III trials for obstructive sleep apnea in addition to obesity and type II diabetes.
Novo Nordisk is also exploring new indications for semaglutide, including MASH, and as a potential treatment for Alzheimer’s disease.
According to Evaluate analysts, the field of oncology continues to be another evolving area within the pharmaceutical industry. While traditional cancer treatments remain relevant, there has been a notable shift in R&D focus towards more targeted approaches.
Antibody-drug conjugates (ADCs) have emerged as a promising avenue in oncology research in recent years and have shown potential in improving treatment outcomes for various types of cancer. Clinical trials examining the efficacy of Merck’s (NYSE:MRK) Keytruda, an immune checkpoint inhibitor, with various ADCs showed promising results compared to standard chemo treatments. An ongoing trial, DESTINY-Breast09, is investigating the combination of AstraZeneca (NASDAQ:AZN) and Daiichi Sankyo’s (OTCPINK:DSKYF) Enhertu and Keytruda in HER2-positive breast cancer, with primary completion data likely due in Q3 2025.
These trials could unlock new treatment options and expand the market for these already successful ADCs.
Similarly, bispecific antibodies have garnered significant attention in the oncology space, demonstrating efficacy in hematologic malignancies. A trial directly comparing Keytruda to Ivonescimab, a bispecific antibody under development by Chinese pharma company Akeso Biopharma (OTCPINK:AKESF) and licensed by Summit Therapeutics (NASDAQ:SMMT), resulted in ivonescimab leading to a better overall survival rate than Keytruda. Further testing is required, but the suggested outcome could impact the future development and potential commercial success of ivonescimab and the bispecific antibody mechanism overall.
Another area of renewed interest in recent months is bispecific antibodies targeting the TIGIT immune checkpoint. While Roche (OTCQX:RHHBF) and its subsidiary Genentech’s tiragolumab faced a setback in a Phase III trial, Gilead (NASDAQ:GILD) and Arcus Biosciences (NYSE:RCUS) have shown promising results with their anti-TIGIT drug domvanalimab.
In a Phase I trial, domvanalimab plus anti-PD-1 antibody zimberelimab led to a 36 percent reduction in the risk of death for patients with advanced non-small cell lung cancer compared to patients who took zimberelimab alone.
“These are the first results demonstrating an improvement in overall survival reported for domvanalimab and zimberelimab,” said Dimitry Nuyten, chief medical officer of Arcus, sharing the results at the Society for Immunotherapy of Cancer (SITC) annual meeting in November 2024.
“They add to the growing body of evidence that domvanalimab…may have a differentiated efficacy, safety and tolerability profile relative to published data from studies with Fc-enabled anti-TIGIT antibodies.”
While immunology remains a key area of pharmaceutical investment following the success of interleukin inhibitors Dupixent, jointly developed and commercialized by Sanofi (NASDAQ:SNY) and Regeneron (NASDAQ:REGN); and Skyrizi, developed and marketed by AbbVie (NYSE:ABBV), the sector is also experiencing shifts.
On January 13, amidst declining demand for Covid-19 and respiratory syncytial virus, Moderna (NASDAQ:MRNA) one of the most prominent names in immunology, cut its sales forecast for 2025. The company expects 2025 revenue of between US$1.5 billion to US$2.5 billion, down from its previous projection of between US$2.5 billion and US$3.5 billion.
Pharma regulation to shape investment decisions in 2025
Changes in the pharmaceutical industry’s heavily regulated environment could impact how companies make investment decisions in 2025. While Big Pharma may be hopeful that President-elect Trump will ease drug price negotiation rules, he has been relatively quiet about repealing that aspect of the Inflation Reduction Act (IRA). His stance on the Affordable Care Act (ACA) is unclear, but he has been vocal about his intentions to trim federal funding for various programs.
The ACA currently provides health insurance coverage to over 45 million Americans. Changes to coverage could have ripple effects throughout the healthcare sector, including the pharmaceutical industry, as reduced coverage could lead to decreased demand for certain medications.
If IRA provisions remain in place or are strengthened, they could put downward pressure on drug prices, potentially impacting company revenues and investor returns. Conversely, if these provisions are weakened or repealed, it could provide a boost to the industry. Investors will need to closely observe political developments and any signals regarding the future of the IRA.
Trump’s unconventional nominees for key health and regulatory positions add another layer of complexity. During his announcement naming celebrity Dr. Mehmet Oz as his choice for administrator of the Centers for Medicare and Medicaid Services (CMS), Trump said Dr. Oz would “cut waste and fraud within our country’s most expensive government agency,” prompting analysts to speculate that he may alter rules on who qualifies for Medicaid and Medicare by instituting work requirements to receive them.
Robert F. Kennedy Jr. (RFK) as Secretary of Health and Human Services (HHS) could impact pharma companies developing vaccines due to his skepticism; however, he has clarified that he supports rigorous research into vaccine safety rather than eliminating them entirely; Research and testing, however, are expensive.
The nomination of Dr. Marty Makary as FDA Commissioner has been met with optimism from some market analysts, who anticipate a potentially more streamlined drug approval process. This could be a positive sign for investors, as faster approvals mean quicker market entry for new drugs and potentially faster returns on investment.
Investor takeaway
Overall, the pharmaceutical industry in 2025 is expected to be characterized by innovation, growth, and transformation. While challenges remain, the industry’s focus on research and development, coupled with advancements in technology and a commitment to patient care, is expected to drive progress and deliver significant benefits to patients worldwide.
Securities Disclosure: I, Meagen Seatter, hold no direct investment interest in any company mentioned in this article.